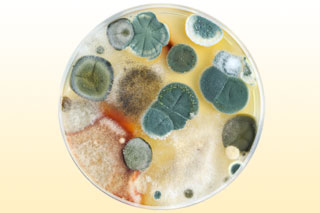
Плесень - причина аллергодерматита Колонии плесневых грибов в чашке Петри

Аллергические прыщи – один из основных симптомов развития аллергодерматита, возникающего вследствие проникновения в организм аллергенов, провоцирующих раздражение кожных покровов. В качестве аллергенов могут выступать продукты питания, медикаменты, шерсть животных, пыль и т.д. Первопричиной высыпаний являются аутоиммунные сбои, способствующие повышению чувствительности кожи.
Основная причина возникновения аллергических прыщей – сбои в работе иммунной системы. В случае попадания аллергенов в кровяное русло организмом продуцируются антитела, которые после связывания с аллергическими агентами образуют иммунные комплексы, способные атаковать здоровые клетки. Впоследствии это приводит к возникновению пузырьков и небольших прыщей на кожных покровах.
К основным провокаторам аллергодерматита относятся:
- плесневые грибы;
- пылевые клещи;
- контрацептивы;
- продукты питания;
- пыльца растений;
- гигиеническая косметика;
- укусы насекомых;
- бытовая химия;
- аутоиммунные заболевания;
- гормональный дисбаланс;
- лекарственные препараты;
- наследственная предрасположенность.
Нередко причиной появления аллергодерматита являются нарушения в работе ЖКТ. Именно поэтому врачи не рекомендуют прибегать к симптоматическому лечению болезни без устранения первопричины ее возникновения.
Клиническая картина
Собственно возникновение сыпи не является прямым доказательством ее аллергического происхождения. Прыщи сопутствуют развитию многих дерматологических, инфекционных и венерических заболеваний. Об аллергической природе кожных воспалений могут свидетельствовать следующие признаки:
- гиперемия кожи;
- отечность лица;
- сильный зуд;
- жжение и шелушение;
- покраснение конъюнктивы глаз;
- заложенность носа.
На фото видно, что аллергические прыщи заполнены водянистым экссудатом, а не гнойными массами. Однако в случае присоединения к болезни бактериальной инфекции может возникнуть абсцесс в пораженных тканях. В подобных случаях терапия аллергодерматита должна быть комплексной. Для устранения неприятных симптомов используют не только антигистаминные, но и противомикробные препараты, ликвидирующие болезнетворные бактерии.
Мнение врачей:
Аллергодерматит на лице – это состояние, при котором кожа лица реагирует на раздражители и аллергены, вызывая различные симптомы. Врачи отмечают, что основными признаками аллергодерматита на лице являются покраснение кожи, зуд, шелушение, отечность и появление сыпи. Часто пациенты также жалуются на сухость кожи и чувство стянутости. Важно обратить внимание, что аллергодерматит может быть вызван контактным дерматитом, атопическим дерматитом или другими аллергическими реакциями. Для точного диагноза и назначения лечения необходимо обратиться к дерматологу или аллергологу.

Диагностика
При подозрении развития аллергодерматита врач не может «на глаз» определить первопричину возникновения прыщей. Чтобы подтвердить или опровергнуть свои подозрения специалист проводит аллергопробы. Это один из самых эффективных методов диагностики болезней аллергического происхождения с возможностью определения и, соответственно, дальнейшего устранения аллергенов.
Для проведения необходимого теста врач наносит небольшое количество жидкого состава с предполагаемым аллергеном на запястье или внутреннюю часть предплечья. Если в течение 5-10 минут на поверхности кожи возникают покраснения или отеки, это свидетельствует о наличии аллергической реакции на раздражитель.
Для 100% подтверждения аллергического происхождения сыпи из носовых пазух аллергика берут мазок для определения флоры в слизистых оболочках носоглотки. Таким образом можно исключить или подтвердить бактериальную или вирусную природу прыщей на лице.
Принципы терапии
Для полной ликвидации симптомов аллергодерматита специалисты проводят курс гипосенсибилизации. Он предполагает использование ряда лечебных мероприятий, нацеленных на уменьшение чувствительности гистаминовых рецепторов к аллергену. Для этого в организм в ничтожно малых дозах вводят аллергены, что помогает скорректировать реакцию иммунной системы в отношении данного раздражителя.
При отсутствии возможности пройти полный курс гипосенсибилизации применяют препараты противоаллергического действия. К числу популярных аптечных средств относятся:
- пероральные препараты – универсальные антигистаминные средства, снижающие чувствительность кожи и купирующие симптомы аллергодерматита;
- линименты и гели – используются в комплексе с другими препаратами, что способствует ускорению процесса регенерации воспалившихся тканей;
- инъекционные растворы – способствуют устранению отечности, прыщей и гиперемии кожи.
Несоблюдение дозировки используемых препаратов может спровоцировать ухудшение состояния здоровья. Нередко в качестве осложнения после курса самолечения возникает эритематозная сыпь не только на лице, но и по всему телу.

Опыт других людей
Признаки аллергодерматита на лице могут проявляться разнообразно и вызывать дискомфорт. Люди, столкнувшиеся с этой проблемой, часто отмечают появление покраснений, зуда и шелушения кожи. Они также могут испытывать отечность и покалывание. Некоторые отмечают появление сыпи или пузырьков. Важно помнить, что реакция кожи на аллергены индивидуальна, поэтому симптомы могут различаться. При подозрении на аллергодерматит необходимо обратиться к врачу-дерматологу для точного диагноза и назначения соответствующего лечения.
Обзор препаратов
Для лечения аллергических прыщей на лице врачи-аллергологи рекомендуют использовать несколько видов препаратов, одни из которых помогут ликвидировать следствие болезни, т.е. высыпания, а вторые – устранить гиперчувствительность кожи. Современная фармакотерапия для лечения аллергодерматита рекомендуют применять такие средства, как:
- «Супрастин» – противоаллергическое средство, относящееся к категории блокаторов Н1-рецепторов, провоцирующих аллергическую реакцию. Устраняет отечность и воспаление тканей;
- «Фенистил» – антиаллергический препарат, обладающий антихолинергическими и антисеротониновыми свойствами. Принцип действия лекарства связан с конкурентной блокадой гистаминовых рецепторов, что способствует уменьшению их чувствительности в отношении медиаторов воспаления;
- «Кестин» – антигистаминное средство, компоненты которого связываются с Н1-рецепторами, что препятствует их соединению с гистамином – медиатором воспаления;
- «Зиртек» – антигистаминное лекарство, обладающее выраженным антагонистическим действием в отношении гистаминовых рецепторов. Угнетает их активность и восприимчивость, что способствует затуханию аллергической реакции.
Курс и длительность лечения аллергодерматита определяется исключительно врачом-аллергологом.
При наличии положительной динамики не рекомендуется приостанавливать терапию, поскольку это чревато рецидивами и обострением аллергии.
Источники: medscape.com, mdlinx.com,
health.harvard.edu.
Частые вопросы
Как понять что у тебя дерматит на лице?
К характерным симптомам дерматитов врачи относят жжение, зуд, покраснение кожи и появление сыпи. Высыпания могут быть ограниченными или распространенными по всему телу. Воспаление кожи негативно влияет на внешний вид человека и ухудшает качество жизни пациента.
Как понять что это аллергический дерматит?
Аллергический дерматит – это воспалительное заболевание кожи с общими симптомами покраснения, зуда, жжения и появления сыпи. На острой стадии заболевания возможно появление мокнущих ран и пузырьков. Возможно общее снижение самочувствия с развитием общей слабости и повышением температуры тела.
Как избавиться от аллергического дерматита на лице?
Антигистаминные препараты, например, цетрин, супрастин, тиосульфат натрия и др. , антибиотики, например, метронидазол 0, 75% (крем) или эритромицин 2% (гель) следует наносить дважды в день до полного исчезновения высыпаний. Ещё
Как выглядит на лице атопический дерматит?
Как выглядит атопический дерматит на лице? Ключевыми признаком атопичной кожи является сильный зуд. Вместе с ним на поверхности лица образуются покраснения, нередко они сопровождаются мокнутием и образованием корочек, поскольку поражение кожи лица характерно для младенческой и детской формы атопического дерматита.
Полезные советы
СОВЕТ №1
При обнаружении признаков аллергодерматита на лице, обратитесь к врачу-дерматологу для точного диагноза и назначения лечения.
СОВЕТ №2
Избегайте контакта с возможными аллергенами, такими как косметика, моющие средства, пыль, пищевые продукты, чтобы предотвратить обострение симптомов.
СОВЕТ №3
Поддерживайте кожу лица в чистоте и увлажненности, используя гипоаллергенные средства для ухода за кожей.